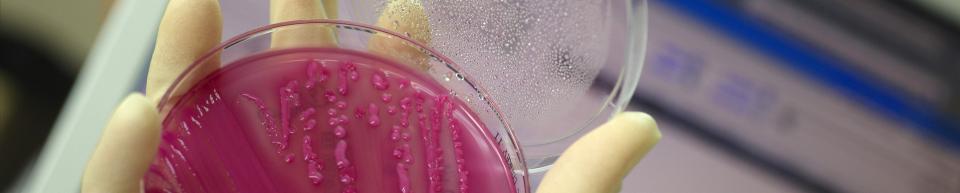
Diagnos-header

Het uitgebreide geautomatiseerde en computergestuurde systeem met testprocessen bevat een LIMS-toepassing (informatiebeheersysteem voor laboratoria). Dankzij dit systeem en de grondige werkzaamheden van onze specialistische medewerkers biedt HIPRA een effectieve en integrale service in minimale tijd.
Een onderzoekshulpmiddel voor het sturen van uw beslissingen
Het nut van de diensten, die door ‘Diagnos’ in de praktijk worden geboden, wordt duidelijk, wanneer we kijken naarde toepassing ervan in verschillende sectoren. 'Startcheck' van STARTVAC®, een dienst, die is bedoeld om aan de hand van melkmonsters de belangrijkste veroorzaker van mastitis bij melkvee te detecteren. ‘Startcheck’ werd bijvoorbeeld gebruikt in prevalentieonderzoek naar koegebonden- en omgevingsbacteriën in tankmelk en dat in verschillende landen (bekijk hier 2 voorbeelden).
Een andere dienst, zoals 'Gumbocheck' van HIPRAGUMBORO®, helpt bij het nemen van vaccinatiebeslissingen bij de ziekte van Gumboro bij pluimvee.
Nieuwste technologie voor het detecteren van DNA in pathogenen
‘Diagnos’ heeft naast de traditionele bacteriologische en serologische analyses onlangs de nieuwste technologie op het gebied van moleculaire biologie toegepast om DNA van pathogenen te detecteren. Deze dienst, in combinatie met een modern online rapportagesysteem, stelt HIPRA in staat om snel te reageren op de vraag naar diagnostiek door dierenartsen.
We hebben onze eigen diagnostische centra
HIPRA beschikt over verschillende diagnostische centra op drie verschillende continenten. Daardoor hoeven we, in tegenstelling tot andere vaccin producenten, geen diensten uit te besteden. In alle diagnostische centra worden monsters getest door middel van goede laboratoriumpraktijken. .
‘Diagnos’ in cijfers
Het vertrouwen, dat deze dienst van HIPRA in de afgelopen 25 jaar heeft gekregen, blijkt wel uit het gebruik ervan: jaarlijks vinden er, naast andere speciale diensten, circa 525.000 serologische analyses, 17.500 moleculaire analyses en 5.100 microbiologische analyses plaats.
Unieke detectiesystemen voor ziekten
Bij HIPRA is innovatie aan de orde van de dag. Daarom wordt ‘Diagnos’ continu uitgebreid met nieuwe en unieke detectiesystemen voor ziekten. Deze systemen verbeteren samen met de vaccins van HIPRA de preventie van besmettelijke ziekten, waardoor economische verliezen, die daaruit voortvloeien worden verminderd.